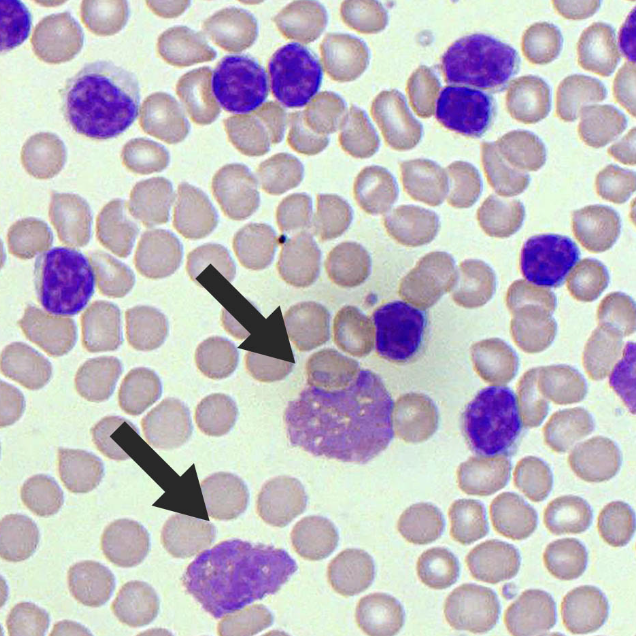

AML buzzword
Auer Rod

‘Tear-drop’ poikilocytes , which diease
M(eye)lofibrosis)

CLL buzzword
Smudge/Smear cell
Which antibiotic
should be avoided
when treating
tonsillitis or glandular
fever
Amoxicillin (rash)
Vestibular Neuritis 3 buzzwords:
Sudden Vertigo
NO HEARING LOSS
Often after Viral infection
For Acoustic Neuroma (Vestibular Schwannoma) 2 buzzwords
Gradual UNILATERAL Hearing Loss
Tinnitus
Sertoli cells=
regulate sperm development in testes
leydig cells=
produce testosterone
Sertoli secrete inhibin… what is decreased?
↓ FSH-
Hirchsprung age
Birth
Duodenal Atresia
1 day
Plyoric Stenosis
1 month
Malrotation/ Volvulus/ intussusception
1 year
Mickel’s Diverlectum
2 years / 2 INCH
Hormonal acne & not pregnant =
COCP
Hormal acne & Pregnancy =
Erythromycin
Cellulitis , main pathogen and treatment
strep pyogenes
Flucloxacillin
Necrotising Fasciitis
main pathogen and treatment
Strep Pyogenes (Fournier’s Gangrene)
surgical debridement
IV Antibioitcs
Chicken Pox + shingles, infectios until?
UNTIL VESICLES HAVE CRUSTED OVER (usually 5-7 days)
Shingles Treatment
Neuropathic agent amitriptyline can be considered
Oral corticosteroids in first 2 weeks if severe pain
Acyclovir within first 72 hours
waxy or shiny umbilicated lesions

Molluscum contagiosum virus
Herpes Simplex, cold sores, treatment
topical acyclovir
Management – topical acyclovir, chlorhexidine mouthwash
HSV-2 = genital herpes
Mx
Management – oral acyclovir
Eczema Herpeticum = HSV-1 or 2
symptoms (2)
treatment (1)
Punched out erosions
Golden crusted lesions
IV Acyclovir




